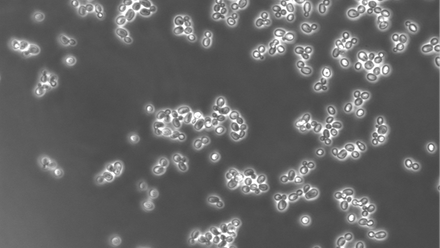
6457_yeast1_256858_crop.png

Bioethnography
The Bioethnography research area at the Microbes and Social Equity (MSE) group merges biological and ethnographic methods to uncover the complex interplay between health, disease, inequality, and the larger historical and life circumstances that shape these phenomena. This interdisciplinary approach illuminates the relational aspects of life sciences, emphasizing how human health and social outcomes are intertwined with microbial actions.
Objectives and Impact
The Bioethnography research at MSE aims to:
- Develop a deeper understanding of how microbial and human interactions are influenced by and can influence social structures and cultural norms.
- Enhance methodologies in health and social sciences by incorporating microbiological perspectives to better address complex issues of health disparities and social justice.
- Engage in public discourse about the implications of microbial research from a socio-ethical standpoint.
Highlighted Research and Discussions
13th April 2022
Deconstructing the Individual
9th February 2022
Diet, Microbial Metabolites, and Cancer Disparities